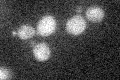
YLR329W
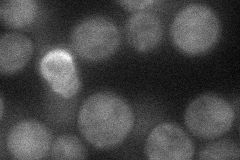
YLR329W
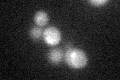
YLR329W
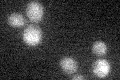
YLR329W

View description
Protein involved in early stages of meiotic recombination; required for chromosome synapsis; forms a complex with Rec104p and Spo11p necessary during the initiation of recombination
Localization:
Intensity:
Fold change:
Significance:
-
C’ GFP library in SD
below threshold16.32 -
N' NOP1pr-GFP in SD
cytosol25.3543 -
N' TEF2pr-mCherry in SD

below threshold0 -
N' NATIVEpr-GFP in SD

missing0 -
N' TEF2pr-VC and Cyto-VN in SD

#N/A0 -
C’ GFP library in SD+DTT
cytosol15.830.96No -
C’ GFP library in SD+H2O2

cytosol15.620.95No -
C’ GFP library in Starvation Media
cytosol17.241.05No -
C’ GFP library on the background of Pup2-DaMP

below threshold -
C’ GFP library on the background of CCT mutant

below threshold16.43521.00655No
